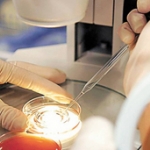

-
Mulher que abrigou 150 gatos abandonados a pedido do município será indenizada
30/09/2020Protetora dos animais chegou a ser taxada como "louca" e "acumuladora de gatos".
-
Condomínio não precisa acionar Poder Judiciário para realizar assembleias virtuais
04/05/2020A magistrada apontou que o condomínio detém competência para realizar a convocação da assembleia e promover a nova eleição através dos meios tecnológicos que já são familiares à população em geral, com a coleta dos votos a distância.
-
Empresas são condenadas em R$ 100 mil por atraso na entrega de imóvel
04/02/2020Decisão é da 1ª câmara de Direito Privado do TJ/CE.
-
Fábrica de tintas é condenada por operar sem licença ambiental
23/07/2018Fábrica atuou por pelo menos três anos sem licenciamento ambiental.
-
Mulher será indenizada após descobrir no divórcio que marido já era casado
23/07/2018Casamento havia sido celebrado nos EUA.
-
Estado do Tocantins deve indenizar paciente derrubada de maca em hospital
23/07/2018Decisão é do juiz de Direito Roniclay Alves de Morais, da comarca de Palmas/TO.
-
Hotel indenizará homem que recebeu multa por infração de manobrista
23/07/2018Carro era da empresa e o homem foi punido com sete pontos na CNH pela infração considerada gravíssima.
-
Professor acusado na internet de exercício ilegal da profissão será indenizado
16/07/2018Após denúncia sem comprovações, professor não conseguiu renovar contrato com faculdade onde lecionava.
-
Passageira será indenizada por "via crucis" após cancelamento de voo
16/07/2018Voo foi cancelado e passageira conseguir chegar ao seu destino aproximadamente 72 horas depois.
-
Imobiliária e corretor indenizarão mulher por falsa promessa em aluguel de imóvel
16/07/2018Decisão é da 30ª câmara de Direito Privado do TJ/SP.
-
Cias aéreas devem indenizar clientes por problemas em embarque e extravio de bagagem
16/07/2018Consumidoras serão indenizadas em R$ 30 mil por danos morais e materiais.
-
Acordo de R$ 850 mil feito em grupo de WhatsApp é homologado pela JT/RR
22/05/2018Termo foi homologado pelo juízo da 3ª VT de Boa Vista/RR.
-
Banco deve indenizar por induzir consumidora a erro na contratação de empréstimo
22/05/2018Cliente foi surpreendida por desconto causado por cartão de crédito que não pretendia contratar.
-
Claro é condenada a ressarcir valores pagos por ponto extra de TV a cabo
22/05/2018Decisão é do TJ/SP.
-
Filho de Tim Maia será indenizado em R$ 30 mil por venda de camisetas com frases do cantor
22/05/2018Magistrado da 4ª vara Empresarial do RJ também determinou que empresa se abstenha de vender produtos.
-
Empresa deve indenizar por manter câmera escondida dentro de banheiro
14/05/2018Decisão é da 1ª turma do TRT da 6ª região.
-
Lei Maria da Penha protege transexual que não realizou cirurgia de mudança de sexo
14/05/2018TJ/DF fixou competência do Juizado de Violência Doméstica em detrimento de juízo Criminal.
-
Homem preso por mandado já cumprido será indenizado pelo Estado
14/05/20182ª câmara de Direito Público do TJ/SC ressaltou a responsabilidade objetiva do Estado.
-
Contribuinte consegue excluir pagamento de IPTU por falta de melhoramentos
14/05/2018Para magistrado, não ficaram demonstradas benfeitorias exigidas pela lei que justifiquem a cobrança.
-
Lei isenta doadores de medula óssea de taxa de inscrição em concursos da União
02/05/2018Candidatos cuja família esteja inscrita no CadÚnico também são isentos do pagamento.
-
Pai de gêmeos consegue licença-paternidade de seis meses
02/05/2018Liminar da 3ª turma do TRF da 4ª região considerou que é dever do Estado assegurar condições ao desenvolvimento das crianças.
-
Claro é condenada por cobrança indevida de aluguel de equipamento
02/05/2018Empresa pagará danos morais e restituirá em dobro o valor da cobrança.
-
Oi indenizará consumidora por cobrança dupla e negativação indevida
02/04/2018Decisão é da juíza de Direito Giani Maria Moreschi, substituta da vara Cível de São José dos Pinhais/PR.
-
Avianca indenizará casal por atraso em voos durante lua-de-mel
02/04/2018Decisão é do juiz de Direito Marcelo Almeida de Moraes Marinho.
-
Empresa é condenada por transportar empregado em compartimento de carga
02/04/2018Trabalhador será indenizado por andar na parte de trás de veículo.
-
Concessionária pagará multa por falta de energia frequente no interior de SP
02/04/2018TJ/SP manteve multa do Procon ao constatar que falhas teriam ocorrido de forma frequente por dois meses.
-
Demora na emissão de certificado de conclusão de curso gera indenização
02/04/2018O certificado chegou ao aluno no curso do processo judicial, o que corroborou o fato da demora imotivada.
-
Comprador será indenizado por atraso na entrega de imóvel
02/04/2018Decisão é da juíza de Direito Francisca da Costa Farias, da 13ª vara Cível de Fortaleza/CE.
-
Condomínios não podem restringir acesso à praia no Guarujá/SP
19/03/2018Decisão é da 3ª câmara de Direito Público do TJ/SP.
-
Juíza retira cobrança do ICMS sobre serviços de streaming em SP
19/03/2018Para magistrada, é forçoso concluir que a transferência de conteúdo digital configura uma circulação efetiva de mercadorias diante dos termos da Constituição Federal.
-
Band, Folha e jornalistas não indenizarão por piada com nome de ginecologista
19/03/2018Em vídeo, José Simão e Ricardo Boechat compararam nome de médico ginecologista com nome de marca de absorvente.
-
Idoso consegue suspender descontos por cartão de crédito que não pediu
19/03/2018O idoso descobriu que contratou cartão de crédito ao invés de um empréstimo consignado.
-
Caixa não terá de ressarcir cliente que caiu no golpe do boleto
19/03/2018Decisão é da 4ª turma do TRF da 4ª região.
-
Condomínio e CPFL devem retirar negativação de mulher que não adquiriu imóvel
19/03/2018Mulher sofreu restrição de crédito por débitos em contas de luz de imóvel que não comprou.
-
67% dos consumidores afirmam conhecer pouco os seus direitos, aponta pesquisa
19/03/2018Pesquisa da Boa Vista investiga o comportamento do consumidor com relação aos seus direitos.
-
Juiz nega medida protetiva a vítima de ameaça: "É lamentável que a mulher não se dê ao respeito"
19/03/2018O magistrado plantonista Joseli Luiz Silva fez a afirmação diante de dois pedidos com base na lei Maria da Penha.
-
Mulher é condenada por usar sobrenome do ex-marido por mais de 15 anos após o divórcio
12/03/2018Justiça determinou a alteração de todos os documentos sob pena de multa diária de R$ 10 mil em caso de descumprimento.
-
Banco pagará R$ 500 mil para família de funcionário usado como escudo humano em assalto
12/03/2018Gerente de banco desenvolveu transtornos emocionais por causa da violência sofrida.
-
Cliente cobrado indevidamente por banco será indenizado
12/03/2018O nome do cliente foi inscrito junto aos órgãos de proteção de crédito em decorrência das cobranças.
-
Companhia aérea indenizará pai de bebê que não entrou no Brasil por falta de documentação
12/03/2018Empresa também foi condenada por perda de conexão causada por atraso em voo.
-
Detran não pode reter veículo apenas pela falta de pagamento do IPVA
12/03/2018Para o juiz de Direito Sério Louzada, o Detran não pode impor restrições ao direito de propriedade sobre veículos.
-
Falta de neve em viagem para esquiar gera indenização por dano moral e material
12/03/2018TJ/DF considerou no caso que a ausência de neve para a prática do esporte não poderia ser caracterizada caso fortuito ou força maior.
-
Condomínio indenizará vigilante vítima de assalto simulado pelo chefe
19/02/2018O TRT da 4ª região manteve sentença que fixou R$ 10 mil de danos morais.
-
TAM é condenada por impedir embarque de menor com familiares
19/02/2018Menor de idade viajaria para os EUA com avó e tio.
-
Rede de postos é condenada por vender combustível com margem de lucro abusiva
14/02/2018Decisão é da 1ª câmara de Direito Público e Coletivo do TJ/MT, que condenou franquia ao pagamento de multa por danos morais coletivos.
-
Homem sem deficiência física pode fazer exame para CNH em carro automático
14/02/2018JF/CE considerou que se for anotada na CNH que a pessoa está apta a dirigir apenas carros automáticos, o fato de ela não estar apta a dirigir carro com transmissão mecânica “é irrelevante”.
-
STJ mantém indenização de R$ 3 mil a pedestre que se acidentou em buraco
05/02/2018Vítima pleiteava majoração do valor; STJ entendeu que quantia seria suficiente para compensar abalo sofrido.
-
Mulher é condenada por atear fogo em pertences do ex-namorado
05/02/2018A decisão é da 8ª câmara de direito Privado do TJ/SP.
-
Mulher indenizará ex-marido por mentir sobre paternidade do filho
05/02/2018Omissão por quinze anos ensejou condenação de R$ 30 mil por danos morais.
-
Facebook é admitido como amicus curiae em ação sobre obtenção de dados de internet no exterior
05/02/2018Relator da ação no STF, ministro Gilmar Mendes entendeu que a empresa pode trazer informações importantes, inclusive sobre a prática e o direito estrangeiros.
-
Record não indenizará homem mostrado em reportagem sobre abusos contra mulheres
29/01/2018A decisão é do TJ/SP.
-
Mulher pode usar nome de solteira mesmo sem pedido quando homologado divórcio
29/01/2018Decisão é da 5ª câmara Cível do TJ/MG, que considerou previsão da lei de registros públicos.
-
TV Record e Rodrigo Faro devem indenizar participante do quadro Arruma Meu Marido
29/01/2018Homem foi submetido a uma cirurgia para retirada de 12 dentes para colocar prótese.
-
STJ suspende ordem de demolição parcial dos Beach Clubs de Jurerê Internacional
25/01/2018Estabelecimentos haviam sido condenados a demolirem estruturas não previstas em TAC firmado com o MPF.
-
Cinépolis deve reconhecer vínculo de estagiária que atuava em limpeza
22/01/2018Estudante auxiliava na faxina de salas e banheiros do cinema.
-
Professor estadual tem jornada reduzida para cuidar de filho autista
22/01/2018Decisão em caráter liminar é do desembargador Peterson Barroso Simão, da 3ª câmara Cível do TJ/RJ.
-
Banco é responsável por assalto em estacionamento terceirizado
22/01/2018TJ/SP entendeu que o local é extensão da agência bancária; banco deverá ressarcir empresa pelo valor roubado.
-
Mulher não deve ser indenizada por fim de relacionamento
16/01/2018Para relator, estão cada vez mais corriqueiros os pedidos de indenização sobre os mais triviais aborrecimentos.
-
Empresa é condenada por usar concorrente para promover próprio site
16/01/2018Decisão reconheceu o desvio de clientela e concorrência desleal por meio do uso de link patrocinado.
-
União indenizará mulher por expedição indevida de CPF
16/01/2018Mulher teve seu nome incluído em rol de maus pagadores por causa de homônima.
-
Hyundai é condenada por vender carro com potência inferior a anunciada
16/01/2018Oficina especializada constatou que a potência do motor era de 105 cavalos e não de 140, como anunciado pela empresa.
-
Município de Sorocaba/SP deve resgatar animais de rua
09/01/2018Decisão é da 9ª câmara de Direito Público do TJ/SP.
-
Construtora indenizará mulher assediada por operário terceirizado
09/01/2018A autora ouvia termos como "gostosa" e "delícia"; ao responder para o trabalhador “cala boca”, foi chamada de “piranha” e “vagabunda”.
-
Lei obriga manutenção de ar condicionado de edifícios públicos e privados
09/01/2018A norma foi sancionada pelo presidente Temer e publicada no DOU da última sexta-feira.
-
Escola usa mediação para solucionar conflitos entre alunos
09/01/2018Professores e alunos receberam cartilhas e cursos explicando o procedimento.
-
Simples atraso na entrega de imóvel não causa dano moral, diz ministra Nancy
13/03/2017Ministro Moura pediu vista em processo que está sendo julgado na 3ª turma.
-
Incorporadora pode reter 30% de valor pago em imóvel em caso de desistência
13/03/2017Para o juiz, não se pode ignorar que a desistência do contrato gera prejuízos à empresa.
-
Consumidor será indenizado em R$ 31 mil por problemas em voos de ida e volta
13/03/2017Indenizações foram fixadas em R$ 15 mil, por atraso do voo, e, em R$ 16 mil, pelo cancelamento na viagem de volta.
-
Direito de ir e vir de executado não pode ser afetado para forçar pagamento de dívida
13/03/2017TJ/SP nega suspensão de CNH e passaporte.
-
Band indenizará homem por expô-lo ao ridículo no programa Pânico
13/03/2017Autor da ação foi vítima de peça durante a Copa do Mundo de Futebol de 2014.
-
Supermercado indenizará por carência de informação em produto que causou queimaduras em consumidores
20/02/2017Casal sofreu queimaduras ao preparar mini churros.
-
Estacionar na frente de garagem gera dano moral
20/02/2017Autor ficou impedido de sair de casa por mais de uma hora.
-
Consumidora pede retirada de negativação e acaba condenada por má-fé
20/02/2017Para a juíza, a simples negativa por parte da autora quanto ao débito não é suficiente para comprovar a inexistência.
-
Homem deve manter pensão de ex-mulher que não retornou ao mercado de trabalho
15/02/2017A mulher recebe pensão desde 95 e alegou impossibilidade de conseguir emprego por problemas de saúde.
-
Mulher processa homem que contratou para matá-la, mas não cumpriu trato
15/02/2017Autora pedia a nulidade do negócio jurídico. O pedido foi julgado improcedente.
-
TJ/SP libera vítima de violência de comparecer a audiência de conciliação de divórcio
08/02/2017Para colegiado, a preferência à conciliação, prevista no CPC, não pode se sobrepor ao princípio da dignidade da pessoa humana.
-
Consumidora que "não se lembrava" de dívida continuará com nome negativado
08/02/2017Juiz julgou improcedente a ação e destacou que, ao dizer que não lembrava, autora não negou a existência da dívida.
-
Google não pode ser responsabilizado por fotos íntimas publicadas por terceiros
08/02/2017Decisão é da 6ª câmara Cível do Tribunal TJ/GO, que negou indenização por danos morais à autora.
-
O Boticário indenizará cliente que sofreu reação alérgica a perfume
01/02/2017Irritações na pele evoluíram para formação de bolhas, pus e queimadura de segundo grau.
-
Universidade deve fazer matrícula de estudante fora do prazo
31/01/2017O prazo da universidade era de apenas 24 horas e a aluna fez diversas tentativas de acessar o site, sem sucesso.
-
Uber não pode ser responsabilizado por atraso e perda de voo
31/01/2017Decisão é do JEC de Brasília/DF.
-
Consumidor só deve pagar comissão de corretagem se houver previsão contratual
31/01/2017Decisão é do TJ/SP.
-
Consumidora receberá de volta IPTU pago antes de entrega de imóvel
26/01/2017Juiz pontuou que responsabilidade pelo pagamento somente ocorre com a entrega do bem.
-
Construtora deve devolver dinheiro pago por imóvel que não foi entregue no prazo
24/01/2017Valor deve ser devolvido com correção e juros. Além disso, os consumidores serão indenizados por danos morais.
-
Caso Mariana: Acordo preliminar prevê R$ 2,2 bi de garantia da Samarco, Vale e BHP Billiton
20/01/2017A JF/MG ainda deverá aprovar acordo.
-
Juiz concede pensão a viúva de ambulante morto no Metrô: "homofobia é epidemia no Brasil"
18/01/2017Juiz concedeu liminar ao reconhecer a responsabilidade da Companhia pela falha na segurança.
-
WhatsApp: Mensagens difamatórias em grupo geram indenização
17/01/2017Rapaz pagará R$ 10 mil a mulher por ofensas.
-
Mulher indenizará ex-marido por esconder verdadeira paternidade de filha
16/01/2017Indenização foi fixada em R$ 39 mil.
-
Juiz suspende passaporte e CNH de mulher inadimplente
13/01/2017Magistrado afirmou ser razoável que, antes de quitar a dívida, ela não viaje ou dirija.
-
Google é condenado em danos morais por não retirar do ar blog considerado ofensivo
13/01/2017Decisão é do TJ/DF, que manteve indenização de R$ 10 mil.
-
GM e concessionária terão que devolver valor pago por carro zero
13/01/2017Com cerca de 10 mil km rodados, o veículo apresentou defeitos.
-
Conversa privada não pode ser usada como prova em ação de guarda de filhos
11/01/2017Pai utilizou tablet do filho para acessar conversas da mãe com outra pessoa.
-
Leilão de imóvel de valor muito superior a crédito trabalhista é suspenso
11/01/2017Desembargadora verificou possibilidade de excesso de execução.
-
Restaurante Paris 6 não consegue exclusividade sobre receita de sobremesa
10/01/2017Para TJ/SP, a famosa sobremesa “Grand Gâteau Paris 6” não é original e sim a “simples colocação de sorvete e creme sobre um petit gateau".
-
Construtora deve indenizar consumidor e devolver valor total pago em imóvel por atraso na entrega
06/10/2016Para o juízo, ficou configurado o dano moral e material com a inadimplência da ré.
-
Embalagens devem informar que valores nutricionais do rótulo variam em até 20%
04/10/20162ª turma do STJ determinou que a Anvisa exija a inclusão de advertência nos produtos.
-
Leilão de imóvel é suspenso por supostas irregularidades de incorporadora
27/09/2016Liminar foi concedida pelo juízo da 43ª vara Cível de SP.
-
Lucro destinado a reinvestimento não deve ser incluído em partilha de bens
31/08/20163ª turma do STJ entendeu que quantia destinada à conta de reserva pertence apenas à sociedade e não ao sócio.
-
Compensação antecipada de cheque pré-datado gera danos morais
22/08/2016Imobiliária deve indenizar consumidora por apresentar cheque antes da data marcada.
-
Tribunais devem observar costumes locais antes de regulamentar vestimentas
11/07/2016CNJ expedirá recomendação aos órgãos do Judiciário.
-
Projeto de lei de SP prevê punição a agressores de animais de estimação
05/07/2016Texto segue para sanção.
-
BB é condenado por confiscar poupança de empregado para quitar diferença de caixa
28/06/2016Condenação foi mantida pela 7ª turma do TST.
-
Consumidor que ajuizou várias ações contra MercadoLivre é condenado por má-fé
24/06/2016Segundo 4ª Turma Recursal dos JECs do RJ, houve "utilização temerária do processo judicial para obtenção de vantagem".
-
Homem que ficou preso indevidamente por nove meses receberá R$ 255 mil
06/05/2016TJ/SP majorou danos morais de R$ 30 mil considerando que Estado "tem a obrigação de pagar a correspondente remuneração à altura da desfaçatez".
-
Casa noturna terá que recolher R$ 159 mil de direitos autorais sobre músicas ao Ecad
15/04/2016Conforme os autos, o estabelecimento executou publicamente, em cerca de 40 festas, diversas músicas sem o devido recolhimento prévio dos direitos de autoria.
-
Policial que levou tiro acidental de colega de trabalho receberá R$ 30 mil do Estado
01/04/2016O policial entrava em um ônibus da corporação junto com outros profissionais, para proceder a deslocamento de rotina, quando a arma de um companheiro disparou acidentalmente e atingiu seu joelho.
-
Cancelamento de compra de carro também encerra financiamento
30/03/2016Decisão é da 3ª turma do STJ.
-
Visualizar e-mail corporativo para acompanhar escala de trabalho não caracteriza sobreaviso
28/03/2016Decisão é do TRT da 3ª região.
-
Telefonia: consumidor deve ser informado quando franquia estiver acabando
24/03/2016Novas regras da Anatel passaram a valer no último dia 10.
-
Lei antiterrorismo é sancionada com vetos
21/03/2016O texto prevê pena de reclusão de 12 a 30 anos em regime fechado a quem cometer atos terroristas previstos na norma.
-
Telefônica responderá por fio solto de poste que provocou acidente com motociclista
18/03/2016Vítima teve graves lesões na mão direita
-
Manutenção de contrato de trabalho não impede pagamento de pensão
17/03/2016Para o relator, o fato de o contrato de trabalho permanecer vigente não exime a empresa pelo pagamento de pagar a pensão mensal.
-
Consumidores lesados em metragem de imóvel serão indenizados por danos morais
16/03/2016Decisão da 3ª turma do STJ, contudo, não concedeu abatimento no valor pago.
-
Julgamente histórico: STJ proíbe publicidade dirigida ás crianças
11/03/2016Caso inédito foi decidido pela 2ª turma do STJ.
-
RedeTV! pagará mais de R$ 1 mi à Band por propaganda enganosa
03/03/2016A empresa paulistana foi condenada por danos morais e materiais pelos dados do Ibope manipulados em 2004.
-
Telexfree não será indenizada por classificação negativa no site Reclame aqui
01/12/2015Empresa integrava lista de empresas "não recomendadas" formada por meio da opinião de usuários.
-
Consumidor chamado de “velho macaco” será indenizado
30/11/2015Valor do dano moral foi majorado de R$ 2 mil para R$ 5 mil.
-
Ofensas e agressões em reunião de condomínio geram indenização
30/11/2015Segunda a juíza, a ofensa a direito da personalidade, clara no caso em questão, enseja reparação por danos morais.
-
Net indenizará idosa religiosa pela cobrança indevida de filmes pornográficos
24/11/2015Juízo do 3º JEC de Goiânia/GO levou em consideração enorme constrangimento e abalo psicológico sofrido.
-
Loja deve indenizar por modificar vestido de noiva às vésperas de casamento
23/11/20154ª turma Recursal Cível do TJ/RS fixou indenização e R$ 7 mil.
-
Noiva será indenizada por receber vestido fora do molde contratado
23/11/2015Momentos antes do casamento, quando da preparação da noiva, vestido não fechou.
-
Feminicídio é qualificadora objetiva para crime de violência doméstica
23/11/2015Entendimento é da 1ª Turma Criminal do TJ/DF.
-
Lojas Americanas terá de indenizar ex-funcionária acusada de "fazer corpo mole" em e-mail
17/11/20151ª turma do TST não conheceu de recurso da empresa e manteve sentença condenatória.
-
Questão de fé não obriga universidade a adaptar-se às diferentes crenças
17/11/2015Colegiado negou pedido de estudante sabatista para alterar horários das aulas às sextas-feiras.
-
Não se deve obrigar pai a amar o filho com ameaça de indenização
17/11/2015TJ/SC negou recurso de filha que pretendia ser indenizada pelo pai por abandono afetivo.
-
Sadia não consegue impedir Seara de divulgar comercial com menção à letra S
13/11/2015Sadia ajuizou ação alegando que teria havido concorrência desleal e tentativa de confundir o consumidor.
-
Consulta de nome de empregado em cadastro de inadimplentes é prática discriminatória
13/11/2015Para TRT da 2ª região, o ato "vilipendia os direitos fundamentais da preservação da intimidade e da privacidade".
-
Plano de saúde deve cobrir despesas com fertilização in vitro
12/11/2015Magistrada considerou fundado o receio de dano irreparável pela condição da paciente, que já tem 40 anos e foi diagnosticada com endometriose
-
Anvisa deve liberar substância extraída da maconha para uso medicinal
12/08/2025Decisão também autoriza importação e prescrição médica de produtos que possuem o composto THC.
-
Confeitaria pagará indenização por doces com aparência inferior à divulgada no Facebook
09/11/2015Decisão é da 1ª Turma Recursal Cível dos JECs do RS.
-
Morar na mesma casa não basta para reconhecimento de união estável
06/11/2015TJ/RS concluiu que provas levam à comprovação de namoro entre as partes, não indicando convivência de marido e mulher.
-
Coluna do Olavo: Especial “Direitos do Consumidor” – La garantia soy yo!
05/11/2015A garantia legal do Código de Defesa do Consumidor e modalidades de garantia.
-
Oferta do Ford Fiesta antes do lançamento do modelo novo não configura propaganda enganosa
05/11/2015Modelo 2007 foi ofertado e, meses depois, o novo modelo foi lançado.
-
Falta de notificação justifica retirada de nome em cadastro de restrição ao crédito
05/11/2015Decisão é da 3ª turma do STJ.
-
Concessionária é condenada por vender veículo com potência inferior à anunciada
03/11/2015Juíza considerou que a empresa tem o dever de reparar o dano material suportado pelo consumidor.
-
Empresas de bebidas devem indenizar por imitação da cachaça Corote
03/11/2015Juíza entendeu que houve uso indevido do nome e concorrência desleal.
-
Ônus de comprovar diferenças a serem pagas em rescisão trabalhista é do empregado
29/10/2015Ex-funcionária não conseguiu comprovar a existência das diferenças devidas.
-
União deve pagar honorários periciais quando reclamante for beneficiária de justiça gratuita
29/10/2015Entendimento é da 5ª turma do TST.
-
Donas de casa também podem ter aposentadoria
27/10/2015Mesmo sem ter renda, elas podem se inscrever no INSS como contribuintes facultativas
-
Funcionário será indenizado por assalto em farmácia
27/10/2015Para a 15ª turma do TRT da 2ª região, é inquestionável a negligência da empresa quanto à segurança de seus colaboradores.
-
Facebook deve indenizar usuário avaliado no aplicativo Lulu
27/10/2015O usuário alegou que seu perfil na rede social foi colocado no aplicativo sem a devida autorização.
-
Coluna do Olavo: Pacote especial - Código de Defesa do Consumidor
29/10/2015Pacote especial Direito do Consumidor: O Código de Defesa do Consumidor.
-
Não recebimento de notificação enseja nulidade da citação
22/10/2015Decisão é da 8ª turma do TST, que reconheceu a nulidade da citação de empresa reclamada em ação trabalhista.
-
Ação contra prefeitura de SP por favorecimento na construção da arena Corinthians é extinta
22/10/2015Juíza não verificou intenção da administração pública em beneficiar o time por meio de lei de benefícios fiscais.
-
Lei Maria da Penha deve ser aplicada em favor de transexual
21/10/2015Magistrada salientou que a expressão "mulher" contida na lei diz respeito tanto ao sexo feminino quanto ao gênero, referente à construção social do indivíduo.
-
Tribunais garantem férias aos advogados
21/10/2015Na maioria das Cortes, os prazos estarão suspensos até 20 de janeiro.
-
Motorista que acompanha abastecimento de caminhão não faz jus a adicional de periculosidade
20/10/2015Decisão é do TRT da 2ª região.
-
Imposição de comissão de corretagem é prática abusiva
20/10/2015Juízo da 5ª vara Cível Guarulhos/SP determinou devolução dos valores pagos por um consumidor com esta finalidade.
-
É legítima a incidência de IPI na saída do produto importado para revenda
19/10/2015Decisão é da 1ª seção do STJ.
-
Garçonete receberá R$ 80 mil por ter de vender vodka adulterada a clientes
19/10/2015Juízo do Trabalho de Florianópolis/SC classificou conduta de casa noturna como "abusiva, perniciosa e mesquinha".
-
Produtora é condenada por música com incitação à violência contra mulher
19/10/2015Decisão é da 2ª seção do TRF da 4ª região.
-
Alterações em plano de saúde empresarial também alcançam aposentados
16/10/2015Decisão é da 3ª turma do STJ.
-
TSE multa Google por não retirar propaganda eleitoral do YouTube
16/10/2015Provedor demorou cerca de três meses para cumprir ordem judicial.
-
CDC não se aplica aos contratos de financiamento de capital de giro
05/10/2015Decisão é da juíza de Direito Maria Fernanda Belli, da 25ª vara Cível de SP, seguindo entendimento do STJ.
-
Termo final de incidência dos juros remuneratórios é o encerramento da poupança
05/10/2015Decisão é da 3ª turma.
-
6ª Câmara mantém decisão que concede auxílio-creche a empregado do sexo masculino
02/10/2015Para colegiado, exigência de que homens comprovem “guarda unilateral dos filhos” desprestigia casamento, união estável e guarda compartilhada
-
Vendedor que não cumpriu orientações do MercadoLivre não tem direito a indenização
02/10/2015Ele enviou produto antes de checar a veracidade das informações do comprador.
-
Mulher consegue alterar nome de Raimunda para Gabriela
02/10/2015Relator considerou que o nome é direito de personalidade e, como tal, merece tutela jurídica especial.
-
Multa por descumprimento de contrato de consumo deve ser aplicada a ambas as partes
01/10/2015Cláusula penal de contrato de compra de imóvel só estava prevista em desfavor do consumidor.
-
Simples Doméstico é disciplinado
01/10/2015Portaria interministerial 822/15, que traz as novas regras, foi publicada hoje no DOU.
-
Senado aprova propostas que atualizam o CDC
01/10/2015Textos estabelecem regas sobre crédito ao consumidor, prevenção ao superendividamento e comércio eletrônico.
-
Contran confuso!
01/10/2015O CONTRAN, após obrigar todo dono de veículo automotor a adaptar-se a norma do uso de extintores de incêndio do tipo ABC, trazendo um gasto extra a muitos proprietários, resolveu facultar o uso deste utensilio veicular.
-
Caixa aumenta juros de financiamentos imobiliários pela segunda vez em 2015
Novas tarifas serão aplicadas apenas para os imóveis financiados a partir de 13 de abril
-
Sacrifício de animais não é compatível com a Constituição de 1988
Esta semana uma leitora do blogue do GERT (www.gertconcursos.blogspot.com.br) em Porto Alegre (RS) escreveu-me a propósito da discussão do PL 21/2015 na CCJ da Assembleia Legislativa daquele Estado.
-
Namorados que moram juntos e pretendem constituir família não têm união estável
O fato de namorados projetarem constituir família no futuro não caracteriza união estável, ainda que haja coabitação. Isso porque essas circunstâncias não bastam à verificação da affectio maritalis.